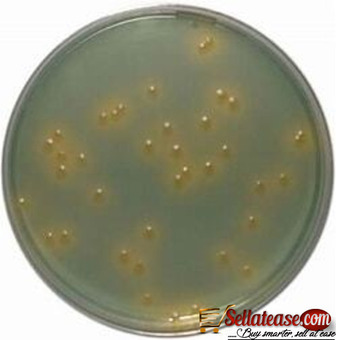

CLED AGAR SOLUTION
Published date: 2023-04-12
Nigeria, Abuja
Plot No.17 Oladipo Diya Street, By Apo Nepa Abuja
Views: 156
Free

09049367703
scantrikmedsupplies@gmail.com
Description
Agar is used as a solidifying agent. Composition of CLED agar Final pH 7.3 +/- 0.2 at 25°C Preparation of CLED agar Weigh and suspend 36 grams of the dehydrated medium in one liter of distilled water
Useful information
- Avoid scams by acting locally or paying with PayPal
- Never pay with Western Union, Moneygram or other anonymous payment services
- Don't buy or sell outside of your country. Don't accept cashier cheques from outside your country
- This site is never involved in any transaction, and does not handle payments, shipping, guarantee transactions, provide escrow services, or offer "buyer protection" or "seller certification"